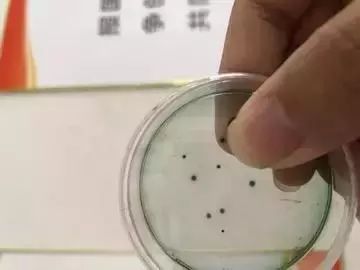
弧菌-水产养殖的杀手，而它是弧菌的最佳克星！

☞水产人都会关注的十大微信公众号
帮邦水产开启鱼虾养殖培训课程,定期邀请行业大咖及实战高手讲解养殖问题,扫描下方二维码,加微信好友,备注养殖品种即可拉您入群!


(加微信好友,做您水产养殖之路的贴心助手)
众所周知,弧菌一直是水产养殖的一大杀手,被称为“水产养殖的癌症”,可弧菌如此可怕究竟是否真的没有任何办法呢,答案是否定的!
我们首先看一个案例:
基本情况
地址:广东省中山市三角镇
池塘面积:11亩
水质监测:氨氮:0.2;亚盐:0.01;ph:8.8;总碱度:100;钙镁:300/108;磷酸盐:0.1;
放苗尾数:45万亩
水深:1.5米
放苗天数:47天
通过调查王老板的土塘,发现对虾游肝胰脏发红的现象,和吴老板沟通以后了解到吴老板处最近连续几天下过雨,经帮帮水产养殖技术部分析后认为,下雨过后容易导致弧菌大量繁殖,远程指导使用弧菌平板检测发现有大量的副溶血弧菌
给出以下解决方案:
1、晚上用帮邦“弧克”4亩/瓶泼洒,杀灭副溶血弧菌、之后重新泼洒帮邦“酵之源”培育有益菌。
2、第二天用帮邦“甘立健”和“生力泰”拌料,调节对虾肝脏,消除对虾体内的弧菌,提高对虾的免疫力,连续三天。
第三天和吴老板联系后吴老板高兴的说经过第二次检测,弧菌已经没有了,“弧克”真有效。

那么弧克到底是什么呢?竟有如此神效:
弧克实际上是50%的过硫酸氢钾复合盐,而我们知道过硫酸氢钾具有很强的氧化性,经过一系列的化学反应,会产生小分子自由基,新生态氧和活性氧衍生物,使菌体蛋白质凝固,从而杀灭病毒。作为新一代杀菌消毒剂,过硫酸氢钾具有安全高效,无刺激,无残留,绿色环保的优势
市面上过硫酸产品众多,我们该如何分辨真正的过硫呢?
首先,我们拿到50%的过硫产品打开瓶盖会有强烈的刺激性气味,其次,过硫遇水会变红,并产生大量泡沫,可以通过底泥氧化实验来检验弧克的强氧化性,取池塘底部淤泥对比如下:


帮邦水产是国内最大的互联网动保、调水和智能设备的电商平台。帮邦砍掉了中间环节,将产品以更低的价格送到您手中,大大降低了养殖成本。最新调水产品已上线,点击原文阅读了解详情!